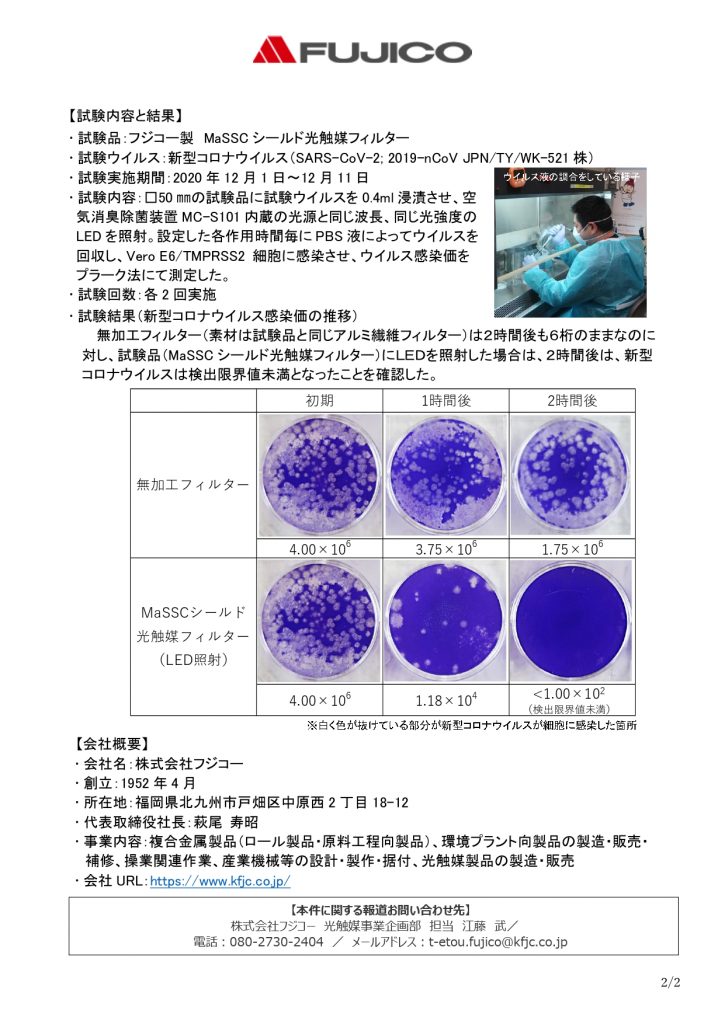

★ 新型コロナウイルス対策 ★
新型コロナウイルス対策 といたしまして
沖縄産業支援センター は
すべての
会議室 ・ 研修室 ・ ホール ・ 展示場 に
(抗ウイルス)
空気消臭除菌装置
を 設置しております
.jpg)
「新型コロナウイルス」
不活性化実証報告を
ご案内いたします


PDFはこちら
.jpg)

PDFはこちら
〇一般駐車場には限りがございます
公共交通機関のご利用、もしくは乗り合わせてお越し下さいませ
〇2025年5月1日(木)より
『会議室(大)(小)、研修室(中)の申込受付期間』が変わりました
※詳細は、こちら (リンク先)
〇2025年5月1日(木)より
『誓約書』の運用方法が変わりました
※詳細は、こちら (リンク先)
〇2025年10月1日(水)より
『会議室(小)キャンセル料金発生の期間』が変わります
※詳細は、こちら (リンク先)